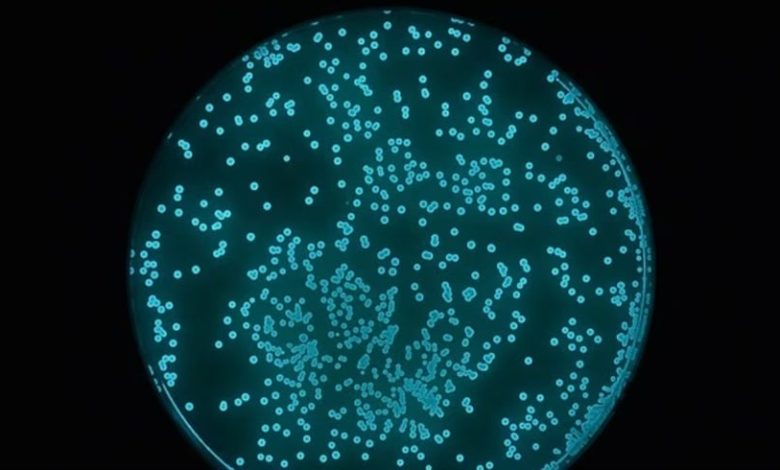

طور مبتكرون لعبة فريدة من نوعها تهدف إلى تشجيع الأطفال على الابتعاد عن الأجهزة الإلكترونية والاهتمام برعاية كائن حي، لكنها قد تثير مخاوف من يعانون رهاب الجراثيم.
اللعبة الجديدة، المسماة (SquidKid) “سكويد كيد”، مستوحاة من حبار هاواي قصير الذيل وعلاقته التكافلية بالبكتيريا المضيئة بيولوجياً.
وتقوم فكرة اللعبة على الحفاظ على حياة مستعمرة بكتيرية حقيقية من خلال توفير الأكسجين والطعام والتحريك المستمر، حيث يكافأ الأطفال بمشاهدة البكتيريا تتوهج بشكل غامض عند العناية بها بشكل صحيح.
وتحتوي اللعبة على مجس قابل للضغط يضخ الهواء في الماء، ما يحافظ على حياة البكتيريا ويزيد من توهجها، لتمنح الأطفال تجربة مشابهة للعبة تاماغوتشي الكلاسيكية، لكن مع كائن حي حقيقي.
وصفت ديدري ني تشونيل، إحدى عضوات فريق جامعة نورث إيسترن المطورة للعبة، SquidKid بأنها “مفاعل حيوي مصغر”، وهو بيئة مضبوطة للحفاظ على الظروف المناسبة لنمو البكتيريا، كما في المفاعلات الحيوية الصناعية التي تُستخدم لصنع الأدوية.
وأضافت ني تشونيل: “كل ما تحتاجه البكتيريا للبقاء على قيد الحياة هو الأكسجين والغذاء ودرجات الحرارة المناسبة والتحريك للحفاظ على اختلاط كل شيء معاً”.
ويؤكد الفريق أن البكتيريا المضيئة المستخدمة في اللعبة غير ممرضة ولا تسبب عدوى للبشر، مع اتخاذ جميع الاحتياطات لمنع تلوث البيئة البكتيرية بسلالات غير مرغوب فيها.
تعتبر SquidKid أداة تعليمية مميزة، حيث يتعلم الأطفال من خلالها نمو البكتيريا وأهمية رعايتها، بالإضافة إلى فهم علم التكافل البيئي والتفكير في الترابط بين الكائنات الحية. وقالت كاتيا زولوتوفسكي، أستاذة مساعدة في التصميم والتكنولوجيا الحيوية: “SquidKid ليس مجرد لعبة عن الأحياء الدقيقة، بل يعلم الأطفال الاعتناء بالبيئة وفهم التفاعلات البيئية والتكافلية”.
ويجدر بالذكر أن اللعبة لا تزال نموذجاً أولياً حتى الآن، لكنها فازت بجائزة العرض المتميز في تحدي التصميم الحيوي لعام 2025، مما يعكس اهتمام المجتمع العلمي بتطوير أدوات تعليمية مبتكرة للأطفال.
لتصلك آخر الأخبار تابعنا على قناتنا على تلغرام: النعيم نيوز
لمتابعتنا على فيسبوك يرجى الضغط على الرابط التالي: النعيم نيوز
كما يمكنك الاشتراك على قناتنا على منصة يوتيوب لمتابعة برامجنا على: قناة النعيم الفضائية
كما يمكنك أيضا الاشتراك بقناتنا على الانستغرام: النعيم نيوز



